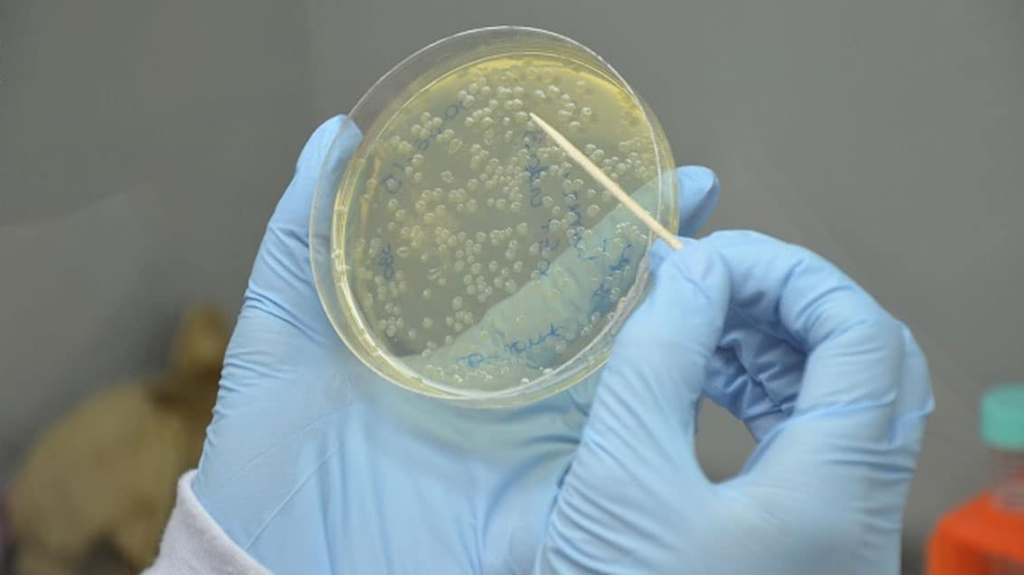
Enzima 1140 640 1024x575

Engineering enzymes to execute reactions not found in nature can address longstanding challenges in synthetic chemistry, such as transforming plant-based oils into helpful biochemicals.
A team of scientists has developed an easy yet effective strategy for developing new enzymes with novel reactivity that can generate beneficial chemical compounds. Consequently, improving their previous job utilizing light to repurpose naturally happening enzymes.
Groundbreaking enzyme research
The study, posted in Nature Catalysis, was guided by Xiaoqiang Huang, a former postdoctoral researcher in the University of Illinois Urbana-Champaign’s Department of Chemical and Biomolecular Engineering (ChBE) and the Center for Advanced Bioenergy and Bioproducts Innovation (CABBI), a U.S. Department of Energy-funded Bioenergy Research.
Huang, presently an Assistant Professor at the Nanjing University in China, executed this operation in the lab of ChBE Professor Huimin Zhao, CABBI’s Conversion Theme Leader and an affiliate of the Carl R. Woese Institute for Genomic Biology (IGB).
In this research, visible light was utilized to excite an engineered ketoreductase enzyme. This enabled a new-to-nature biocatalytic reaction called an asymmetric radical conjugate addition. This reaction is extremely difficult to achieve by chemical catalysis.
Benefits of enzymatic reactions
Catalysts are substances utilized to quicken chemical reactions. In living organisms, protein molecules named enzymes catalyze reactions in a process named biocatalysis. Researchers have started using biocatalysis to synthesize essential substances, as its high selectivity enables them to deploy enzymes to act upon specific substrates and produce target products.
One more benefit is that enzymatic reactions are very tenable. They are relatively inexpensive, ingest reduced energy levels, and do minor damage to the environment, unlike chemical catalysts, which usually need organic solvents, warmth, and high pressure to work.
Still, enzymes are complex to work with. They usually are limited to catalyzing reactions encountered in nature, meaning researchers frequently battle to locate the excellent biocatalyst to fulfill their requirements. Zhao’s laboratory has concentrated on steering biocatalysis with visible light, a technique called “photobiocatalysis,” to create new enzyme reactivity.
In previous research, Zhao and Huang created a visible light-induced reaction using an enzyme called ene-reductase (EMERGENCY ROOM) as a biocatalyst to generate high yields of valuable chiral carbonyl substances, which have potential applications for the production of high-value chemicals.
Inside the molecules
The new research improves that work, using photobiocatalysis on a divergent enzyme family– nicotamide-dependent ketoreductases produced by bacteria– and a different chemical mechanism to produce one more type of chiral carbonyl substance called α-chiral esters. Through the illumination and evolution of ketoreductase, the team accomplished an enantioselective biocatalytic Giese-type radical conjugate addition to transform fatty acids into α-chiral esters, Zhao claimed.
Enantioselectivity is the degree to which an enantiomer– one of a pair of compounds that are mirror images of each other– is preferentially produced in a chemical reaction. Chirality is a fundamental feature of organic substances, which substantially influences the properties of molecules, and its effects are enormous in many camps involving biology, medicine, and material science.
As an example, the diverse stereochemistry of organic molecules (the spatial arrangement of atoms and their effect on chemical reactions) not just considerably improves the magnificence of the biological world but also plays a profound function in many biological activities such as molecular communication, he stated.
The discoveries’ applications
The findings supply practical applications for CABBI’s job to create biofuels and biochemicals from crops like miscanthus, sorghum, and energy cane instead of petroleum. The new biocatalytic transformation might utilize the fatty acids that CABBI is generating from those plants as starting materials to synthesize value-added bioproducts– such as ingredients for soaps or skin-care items– in an ecologically friendly way.
“Although we did not target a specified product for further application, this work gives a practical new method that can be strongly put on upgrading fats,” Zhao said. Enzymes are the workhorses for organic synthesis of fuels and chemicals from renewable biomass.
“One of the important scientific adjustments in CABBI’s conversion research, or bioenergy research in general, is the absence of known enzymes with the wished task and substrate uniqueness for the synthesis of target fuels and chemicals. For that reason, there is an emergent need to develop new techniques to find out or engineer enzymes with wanted function or reactivity.”
Read the original article on PHYS.
Read more: An Improved Way to Develop Compounds For Pharmaceuticals.
